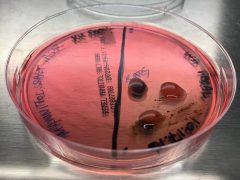
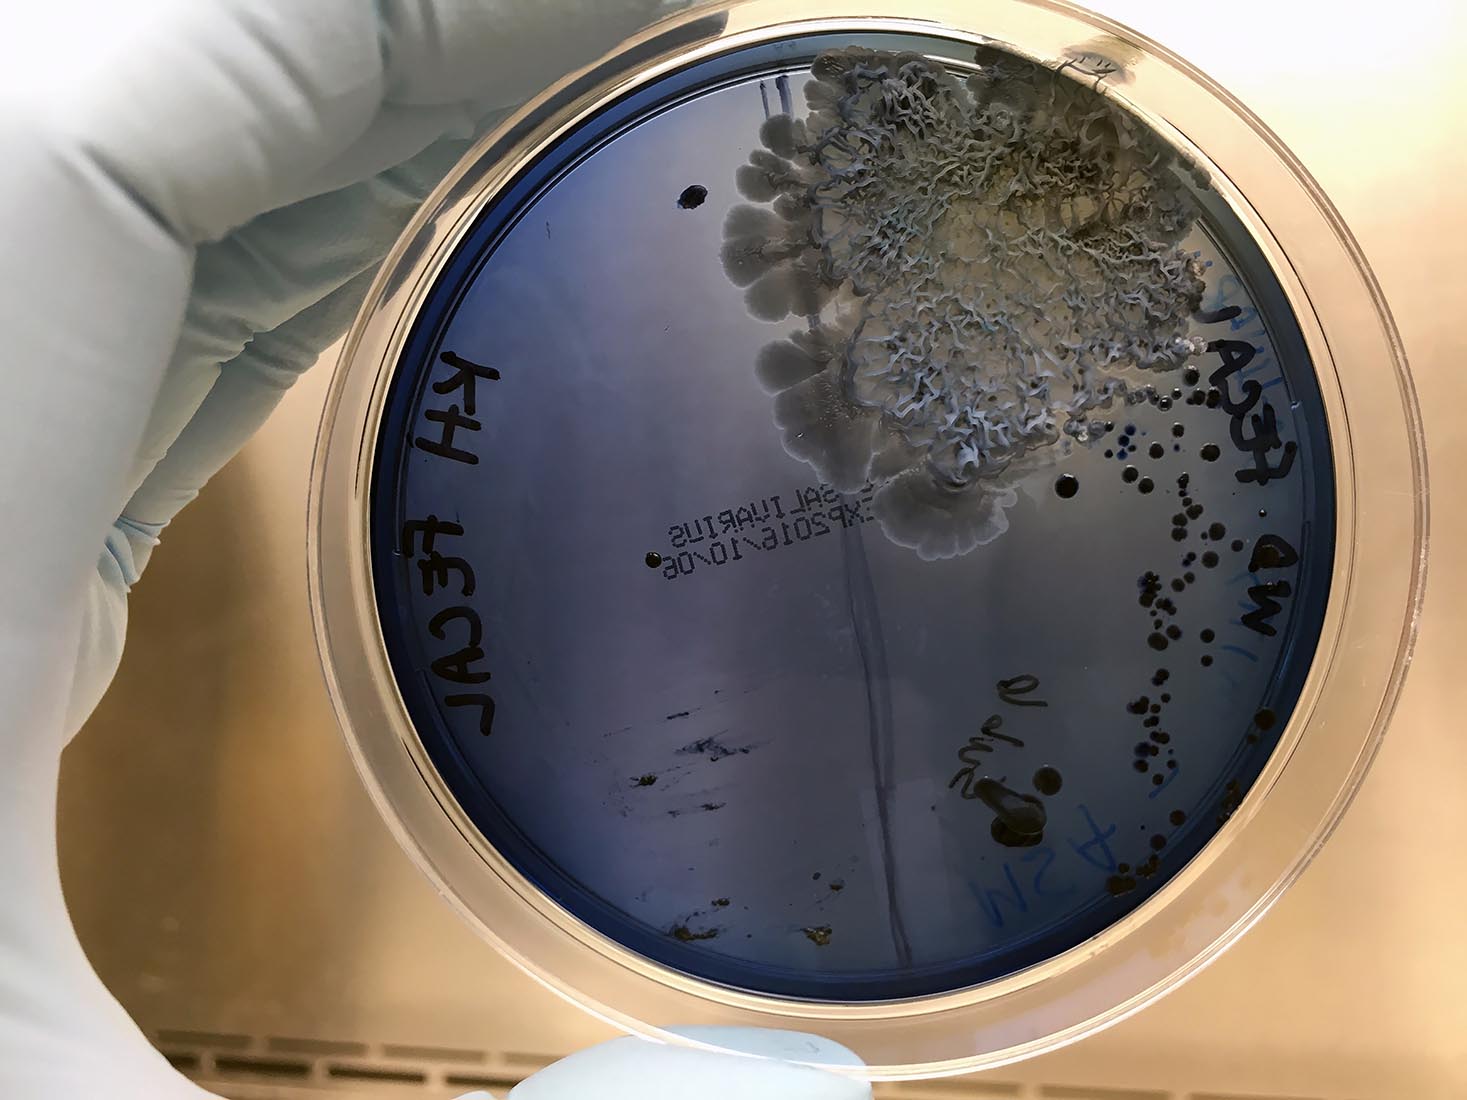
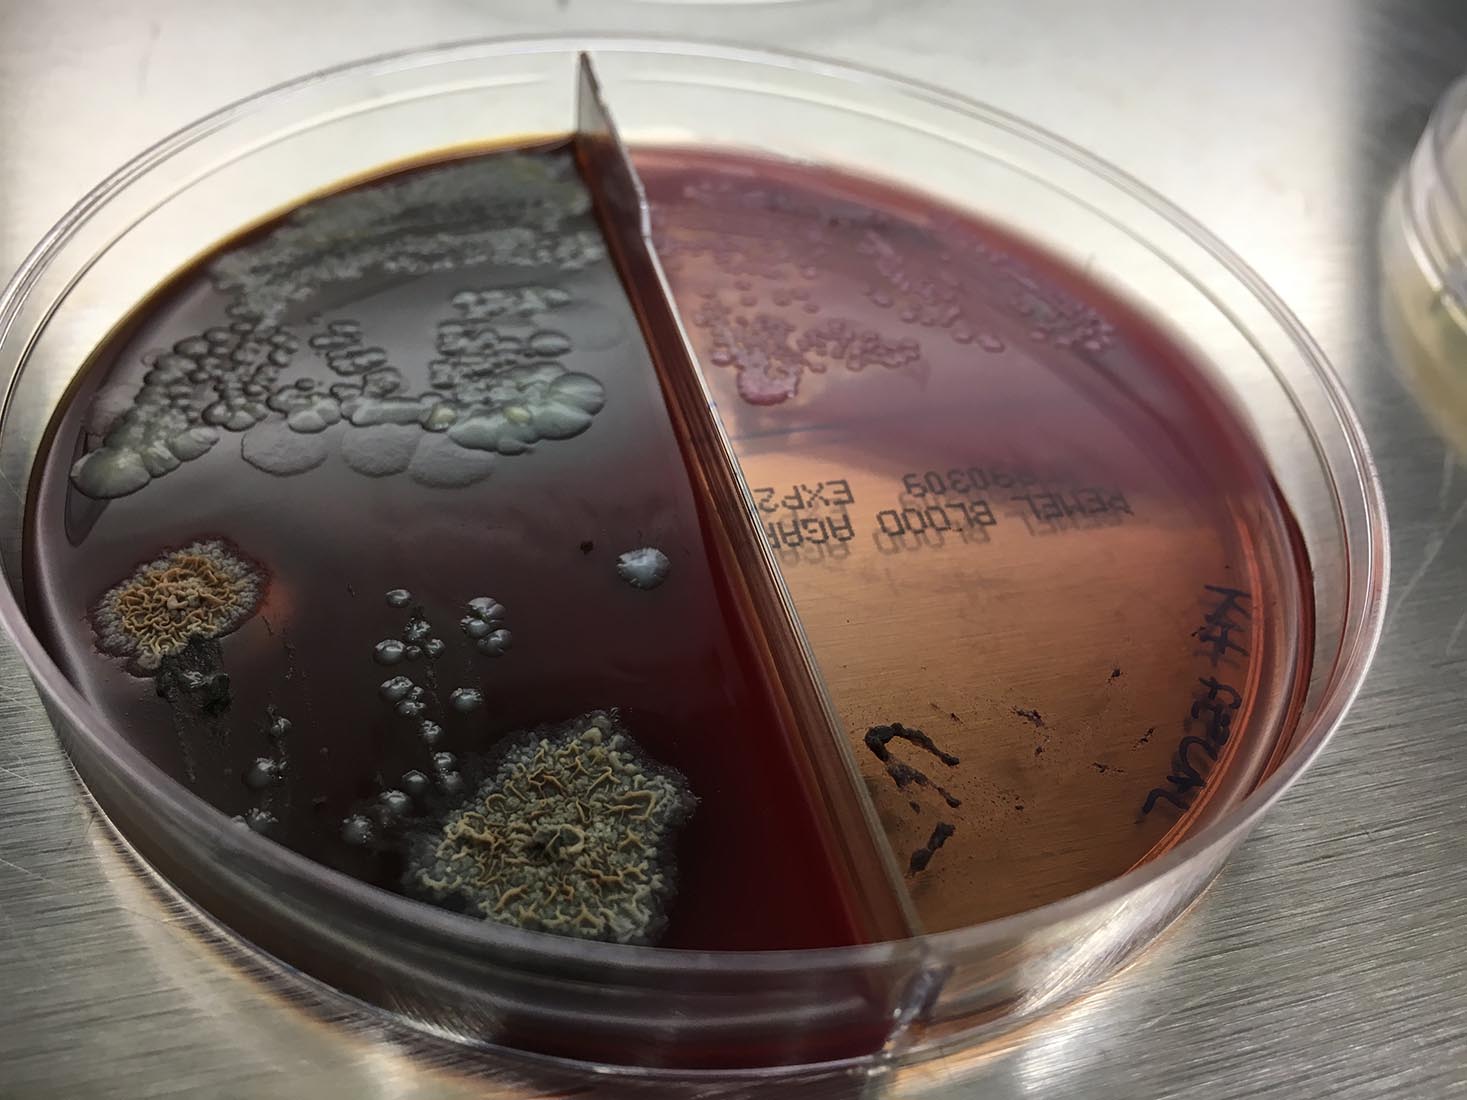
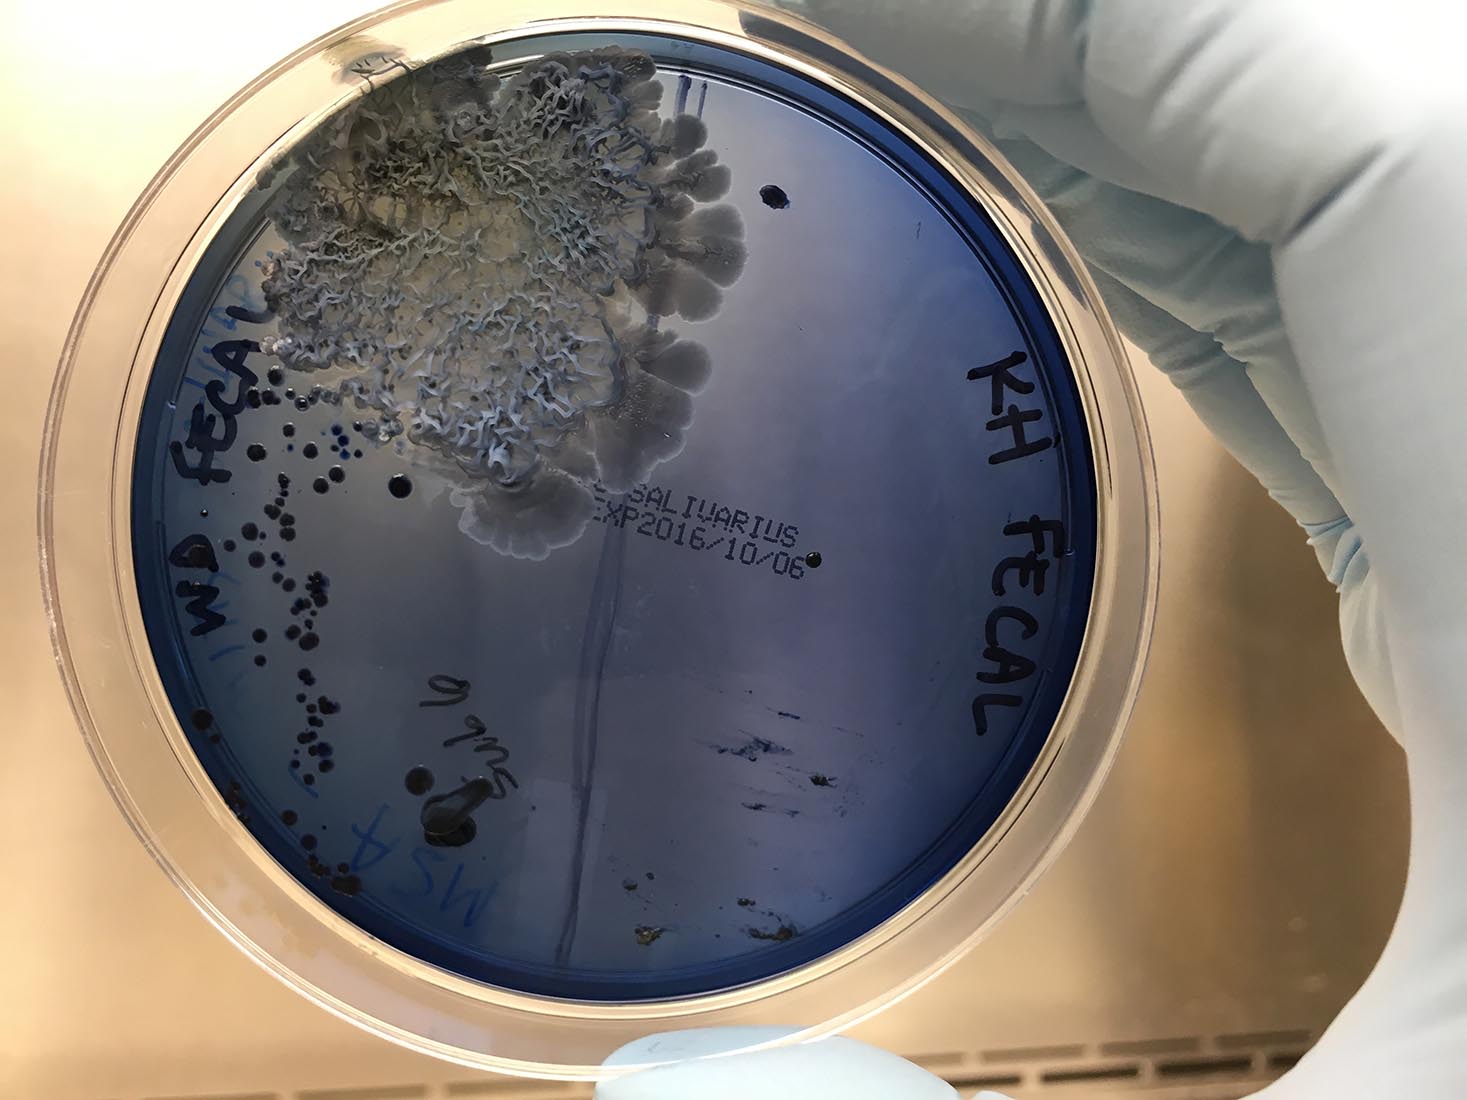
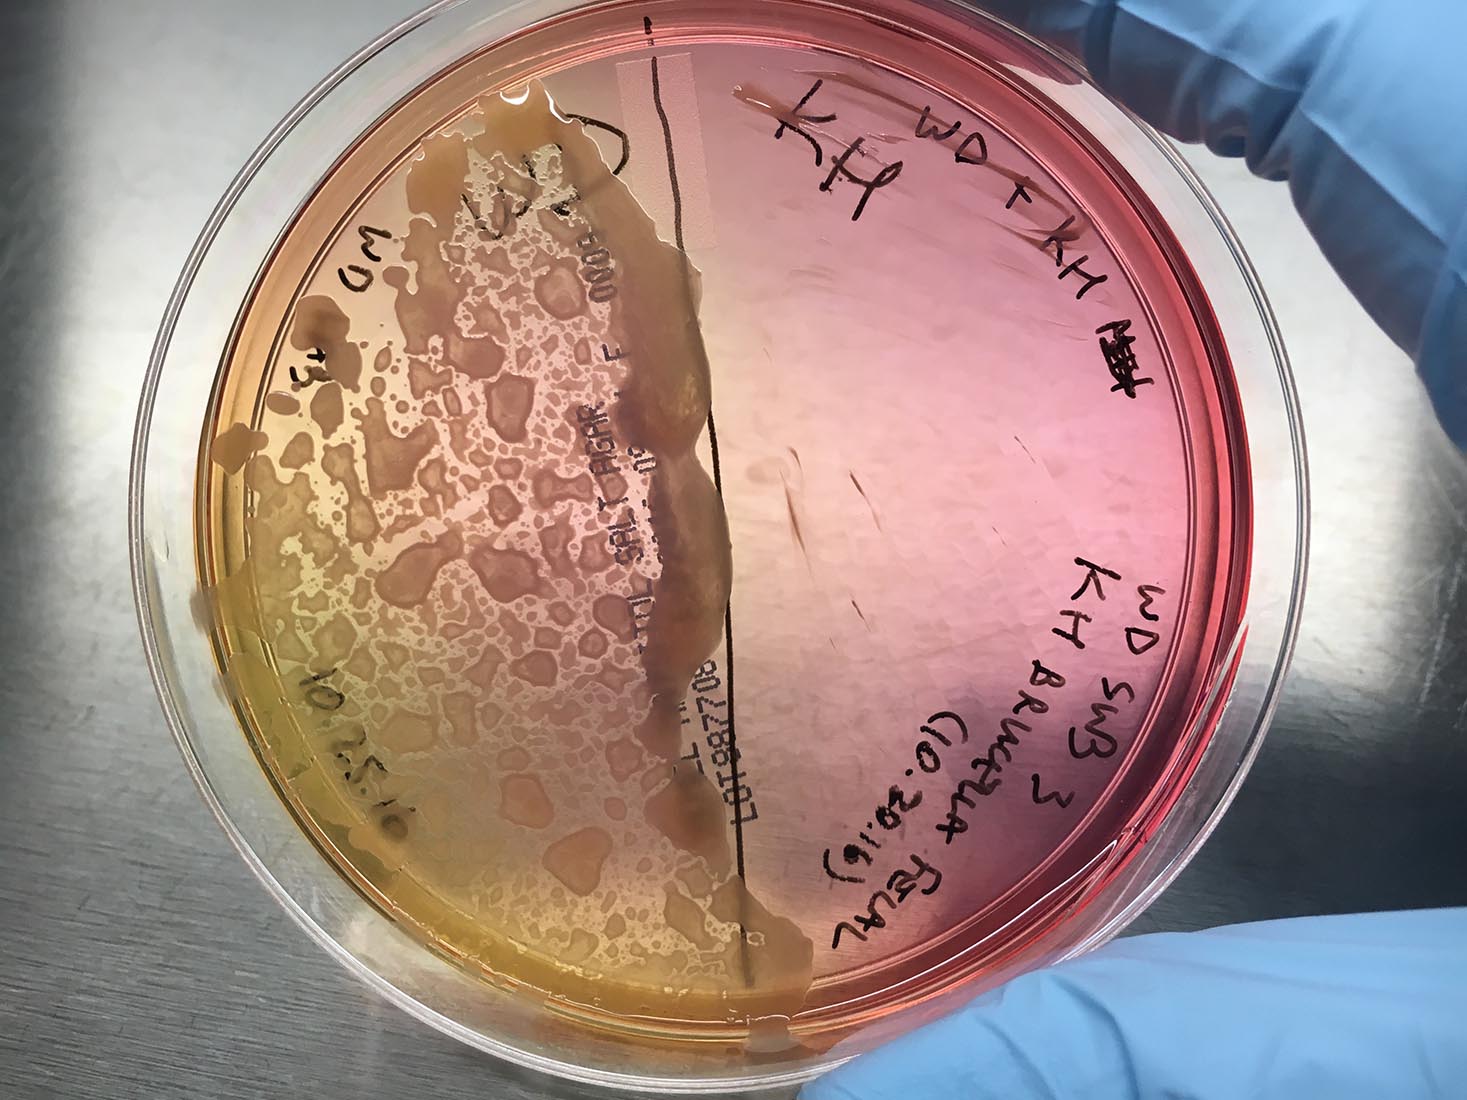

2017
Photo research series on missing microbes
Kathy High and William DePaolo plated their own fecal samples side by side on agarpetri dishes. In plate auger plate, DePaolo’s bacteria was productive and diverse. But High’s side of the petri dish repeatedly came up empty, evidence of a condition of “dybiosis” – or missing microbes.
Is this our 21st century human condition?
Kathy High and William DePaolo, DePaolo Lab, UW
Photographer: Kathy High







2017
Kathy High and William DePaolo plated their own fecal samples side by side on agarpetri dishes. In plate auger plate, DePaolo’s bacteria was productive and diverse. But High’s side of the petri dish repeatedly came up empty, evidence of a condition of “dybiosis” – or missing microbes.
Is this our 21st century human condition?
Kathy High and William DePaolo, DePaolo Lab, UW
Photographer: Kathy High